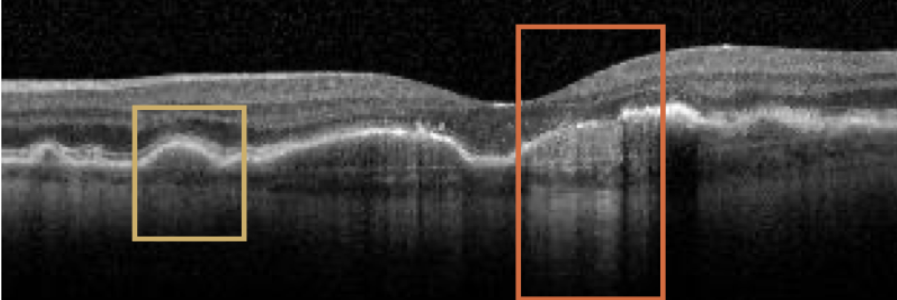
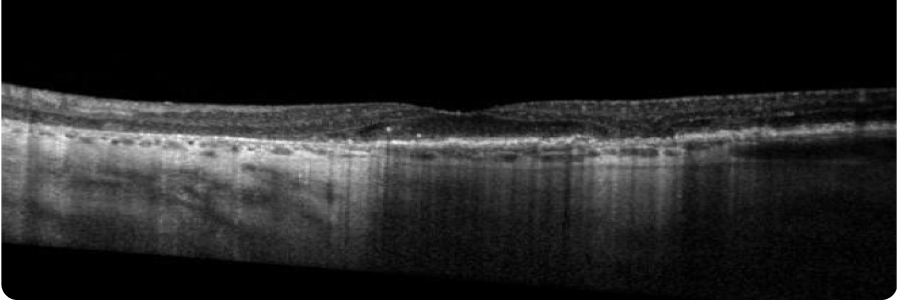
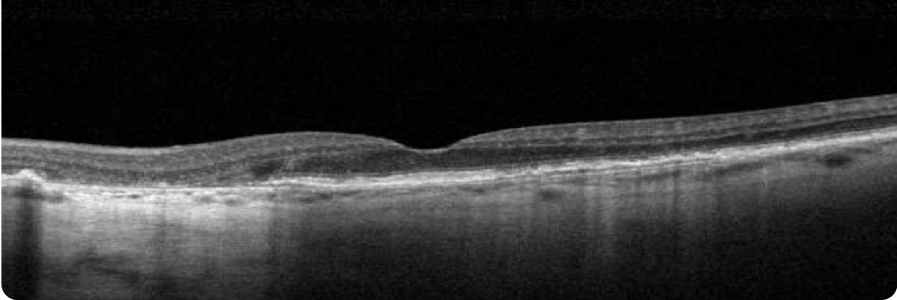
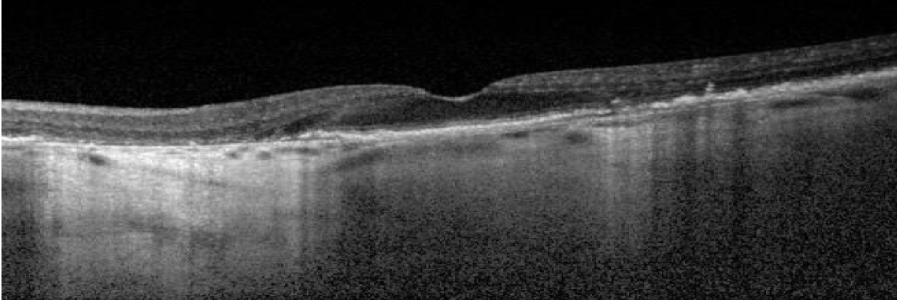

When to refer geographic atrophy patients

It is critical to recognise geographic atrophy at first sight
Geographic atrophy is characterised by regions of atrophy, resulting from loss of photoreceptors, retinal pigment epithelium, and the underlying choriocapillaris. This results in a choroidal hypertransmission defect on Optical Coherence Tomography.1
Baseline

BCVA: 6/7.5
Choroidal hypertransmission defect is a sign of atrophy.
Year 4

BCVA: 6/15
Lesion has grown closer to the fovea as shown by larger area of hypertransmission on OCT. However, BCVA has only declined slightly as fovea is still intact.
Images courtesy of Dr Mohammad Rafieetary, OD, Charles Retina Institute.
Proactively identify patients with geographic atrophy
Ophthalmologists and optometrists play a key role in early detection, monitoring, and timely referral of appropriate GA patients.2
Explore the following patient case studies to see different examples of patients with geographic atrophy who should be referred.
The following case studies employ various imaging techniques for GA, including fundus autofluorescence (FAF), near-infrared reflectance (NIR), and optical coherence tomography (OCT). OS (ocular sinister) refers to an image of the left eye.
GA progression is constant and irreversible1,3–5
Patient case study 1
Edwin G.
75 years old
(Hypothetical patient)
Medical history:
- Family history of AMD
- Former smoker
- BMI 27
- At baseline, patient’s findings are consistent with intermediate dry AMD. Four years later, OS has progressed to GA with foveal involvement
BASELINE VISIT
- BCVA: 6/12
- Visual function: Patient is minimally symptomatic with some difficulty seeing at night
FAF

Hyperautofluorescence indicates areas at high risk for atrophy.1
NIR

OCT
4 YEARS AFTER BASELINE VISIT
- BCVA: 6/45
- Visual function: Patient has stopped driving, and has trouble reading and seeing faces
FAF OS

NIR OS

OCT OS

Large area of atrophy associated with choroidal hypertransmission on OCT
Images courtesy of Mohammad Rafieetary, OD, Charles Retina Institute.
Visual acuity is poorly correlated with lesion size in earlier stages of the disease3,7
Change in visual acuity may not fully capture disease progression;3,7 visual function continues to decline as lesions grow.3,8,9
Patient case study 2
Isabella C.
80 years old
(Hypothetical patient)
Medical history:
- No family history of AMD
- Non-smoker with exposure to second-hand smoke
- Diabetes, hypertension
- BMI 28
- Patient at baseline has a large area of GA, however, BCVA is relatively unaffected due to foveal sparing
- Within 4 years, OS GA has progressed, but BCVA has only declined slightly as fovea is still intact
BASELINE VISIT
- BCVA: 6/7.5
- Visual function: Patient requires assistance from a caregiver on some activities (eg, cooking, driving), since pericentral vision is lost due to GA
FAF

NIR

OCT
4 YEARS AFTER BASELINE VISIT
- BCVA: 6/15
- Visual function: Although patient maintains relatively good BCVA, she has poor visual quality. Patient relies heavily on caregiver for assistance with many activities of daily living
FAF

NIR

OCT

Although there is significant atrophy, the fovea remains relatively spared from GA.
Images courtesy of Mohammad Rafieetary, OD, Charles Retina Institute.
Multifocal configuration, large size, and non-foveal involvement are predictors of faster GA progression1,3,10
Patient case study 3
Carla L.
82 years old
(Hypothetical patient)
Medical history:
- Family history of AMD
- Former smoker
- Hypertension, hyperlipidaemia
- BMI 33
- Patient has GA with multifocal lesions outside the fovea at baseline. These lesions tend to progress faster than unifocal, foveal lesions
- Within 2 years, the areas of atrophy have grown and coalesced. However, the fovea still remains intact resulting in mild alteration of BCVA
BASELINE VISIT
- BCVA: 6/9
- Visual function: Patient has dark adaptation issues and some difficulty reading
FAF

NIR

OCT
2 YEARS AFTER BASELINE VISIT
- BCVA: 6/12
- Visual function: Patient no longer feels comfortable driving although she is legally able to. Patient relies heavily on assistance from caregiver with some activities of daily living
FAF

Clear progression of perifoveal GA two years later.
NIR

OCT
Images courtesy of Mohammad Rafieetary, OD, Charles Retina Institute.
Access all three case studies below
Join us on our journey in geographic atrophy
Be the first to receive the latest geographic atrophy news
Thank you for submitting your details.
Please check your inbox for confirmation


What is geographic atrophy?
By 2040, 18 million people may be facing progressive, irreversible, and permanent vision loss.1,11
Geographic atrophy progression is constant and irreversible
While lesion growth in geographic atrophy may appear to proceed slowly, disease progression is constant and irreversible.3–5,12
Patients can lose more than their sight to geographic atrophy
They may have difficulty with independence, relationships, and everyday activities.13–15
References
- Fleckenstein M, et al. Ophthalmology. 2018;125(3):369–390.
- American Optometric Association. Comprehensive adult eye and vision examination. 2015. Available at: https://www.aoa.org/documents/EBO/Comprehensive_Adult_Eye_and_Vision%20QRG.pdf (accessed June 2023).
- Boyer DS, et al. Retina. 2017;37(5):819–835.
- Lindblad AS, et al. Arch Ophthalmol. 2009;127(9):1168–1174.
- Holz FG, et al. Ophthalmology. 2014;121(5):1079–1091.
- Shijo T, et al. Sci Rep. 2022;12(1):4715.
- Heier JS, et al. Ophthalmol Retina. 2020;4(7):673–688.
- Kimel M, et al. Invest Ophthalmol Vis Sci. 2016;57(14):6298–6304.
- Sadda SR, et al. Retina. 2016;36(10):1806–1822.
- Wang J, Ying G. Ophthalmic Res. 2021;64(2):205–215.
- Wong WL, et al. Lancet Glob Health. 2014;2(2):e106–e116 and supplementary appendix.
- Sunness JS, et al. Ophthalmology. 2007;114(2):271–277.
- Sivaprasad S, et al. Ophthalmol Ther. 2019;8(1):115–124.
- Jones D, et al. Invest Ophthalmol Vis Sci. 2022;63(7):A0145.
- Apellis & The Harris Poll. 2022. Geographic Atrophy Insights Survey (GAINS).
EU-GA-2300007 April 2026